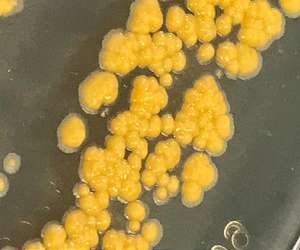

| . |  |
. |
| . |  |
. |
|
by Staff Writers Tampa (AFP) July 24, 2018
More than 1,000 species of animals would face serious threats to their survival if US President Donald Trump's proposed border wall with Mexico is built, scientists warned on Tuesday. Iconic creatures such as the Peninsular Bighorn sheep, Mexican gray wolf and the Sonoran pronghorn antelope -- all of which are already endangered -- would see their populations dangerously fragmented by a wall, said the letter published in the journal BioScience. Jaguars (panthera onca) and ocelots (leopardus pardalis) would be among the species that would have "residual US populations" covering 7,800 square miles (20,000 square kilometers) or less, raising their risk of dying off completely in the United States. More than 2,700 global scientists signed on to the letter by lead author Robert Peters of Defenders of Wildlife, a conservation group. The letter details threats to biodiversity along the 2,000-mile (3,200-kilometer) US-Mexico border, which Trump wants to wall off in an effort to stop the flow of illegal migrants. "Fence and wall construction over the past decade and efforts by the Trump administration to complete a continuous border 'wall' threaten some of the continent's most biologically diverse regions," said the letter. "Already-built sections of the wall are reducing the area, quality, and connectivity of plant and animal habitats and are compromising more than a century of binational investment in conservation," it added, lamenting that "political and media attention... often understate or misrepresent the harm done to biodiversity." When populations of animals are fragmented, they have a harder time finding mates, food, water and safe habitat, and face higher risks of extinction. "Cut off like this, the bighorn and other animals and plants will become zombie species -- populations that are demographically and genetically doomed," said co-author and Stanford University biologist Rodolfo Dirzo. The border region includes more than 1,000 animals and over 400 plants. A total of 62 of these species are "already listed as Critically Endangered, Endangered, or Vulnerable by the International Union for Conservation of Nature," said the letter. Co-author and Stanford University professor of biology Paul Ehrlich said in a statement that the wall, and "the accompanying construction and maintenance infrastructure would be a crime against biodiversity." The letter urged US officials to identify species at risk from the wall construction, design barriers that allow wildlife to pass through as much as possible, and purchase or restore replacement habitat when environmental harm is inevitable. As it stands, a US law passed in 2005 gives the Department of Homeland Security authority to waive protections such as the Endangered Species Act if they are deemed to be factors in slowing the wall's construction. Trump's wall has still not secured major financing. A bill that would have included $25 billion to fund it failed last month in the House of Representatives.
Nature's antifreeze inspires revolutionary bacteria cryopreservation technique Warwick UK (SPX) Jul 23, 2018 The survival mechanisms of polar fish have led scientists at the University of Warwick to develop of a revolutionary approach to 'freeze' bacteria. The new technique could radically improve the work to store and transport human tissue. Researchers from the Department of Chemistry and Warwick Medical School have established a way to cryopreserve (or 'freeze') a broad range of bacteria using synthetic reproductions of the natural antifreeze proteins found in polar organisms. They found t ... read more
|
|||||||||||||
| The content herein, unless otherwise known to be public domain, are Copyright 1995-2026 - SpaceDaily. All websites are published in Australia and are solely subject to Australian law and governed by Fair Use principals for news reporting and research purposes. By using our websites you consent to cookie based advertising. If you do not agree with this then you must stop using the websites from May 25, 2018. Privacy Statement. Additional information can be found here at About Us. |